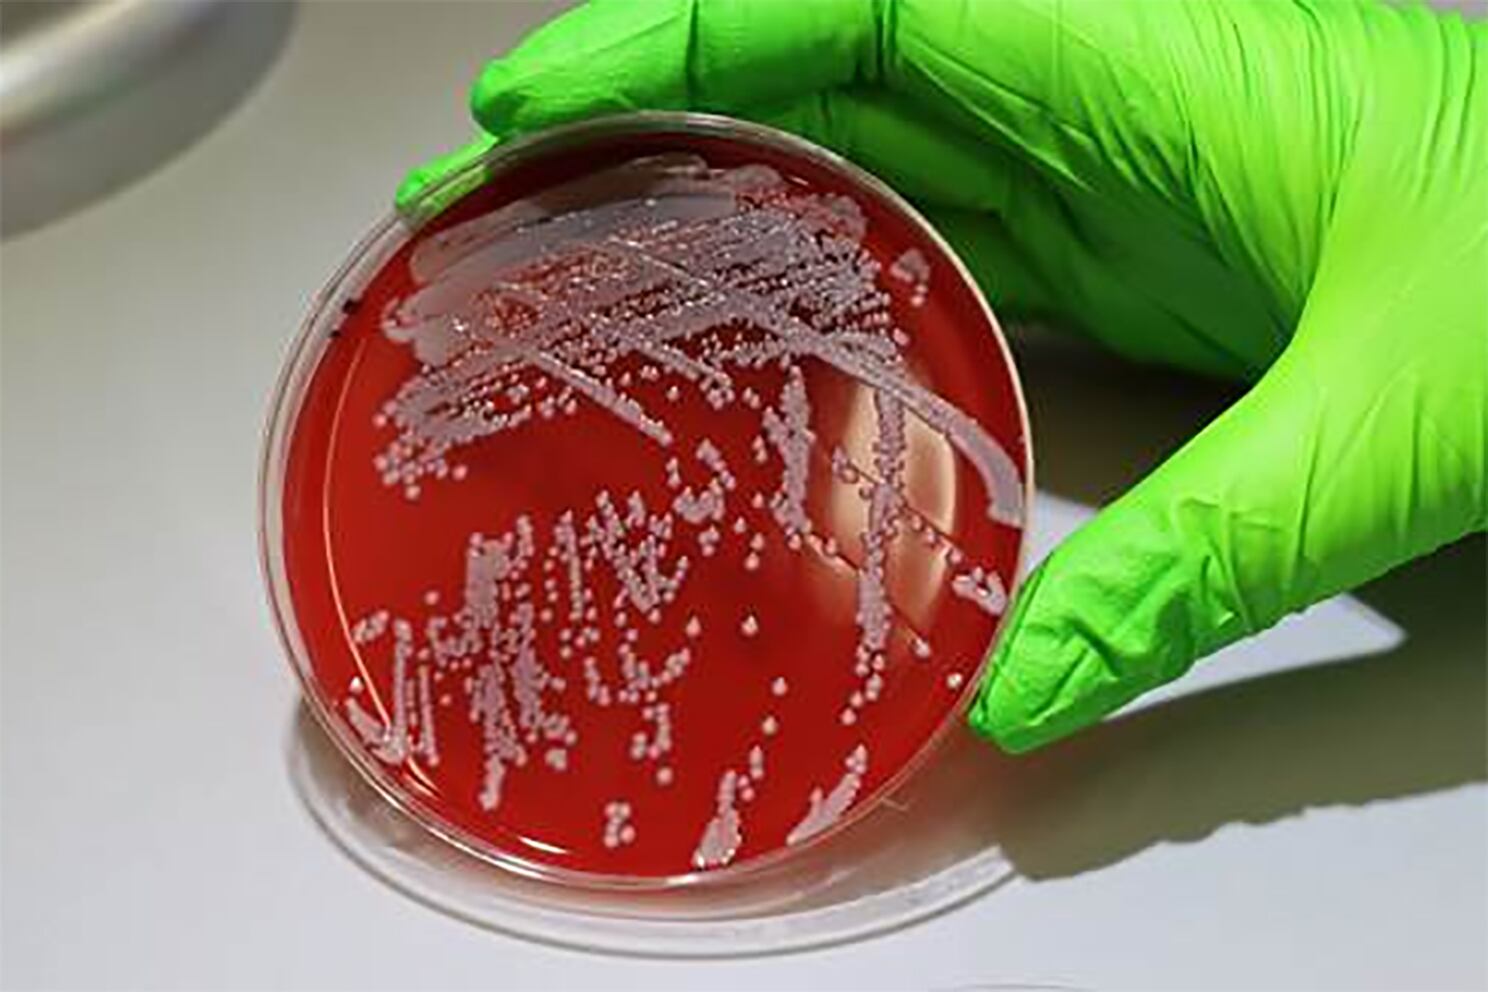

Alerta por las superbacterias, resistentes a los antimicrobianos tradicionales
El superenemigo de la salud
Un estudio de Reino Unido indicó que si se abandonan las políticas para combatir la resistencia antimicrobiana, aumentarán las muertes por esta causa y tendrá un impacto negativo para las economías. Organismos no descartan una nueva pandemia a mediano plazo.